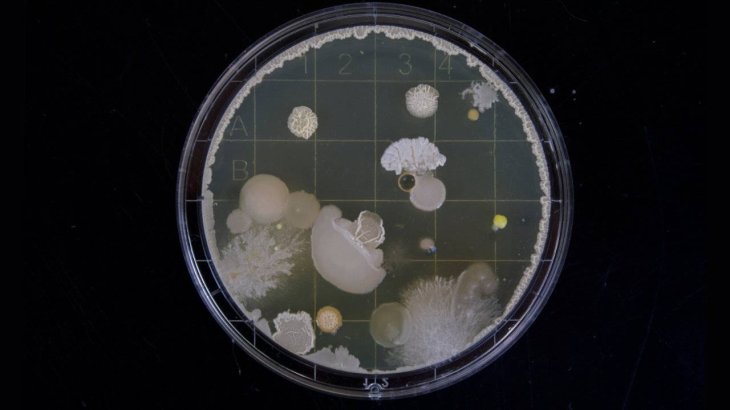
Bacteria-bombs-detection

These Bacteria Are Programmed To Detect Bombs Buried Underground
Aadhya Khatri - Nov 15, 2019
The first type of bacteria will detect explosive buried underground and the second is programmed to show a glowing light that is visible from the surface
Raytheon, a major U.S defense contractor, is collaborating with DARPA (stand for Defense Advanced Research Projects Agency) in developing a new method to detect explosive buried underground. What they are testing with is bacteria.
This project is a contract form the agency, and it also has the participation of Worcester Polytechnic Institute, which will work with Raytheon to program two bacteria strains to identify bombs underground.

The DARPA has contacts with various private companies to develop new technologies for homeland security and the military. What they are interested in ranges from new weapons to more effective medicines.
According to Raytheon, the first type of bacteria will detect explosive buried underground and the second is programmed to show a glowing light that is visible from the surface whenever bombs are found.
This is not the first time the idea of using bacteria to identify bombs is developed; however, things get harder when the explosives are buried. These microorganisms will have to travel deep enough to find signs of bombs while their light must be able to be detected by people on the surface to inform those who are in charge of monitoring them.
This project is possible is because of synthetic biology, which allows for DNA modifying using electrical engineering and computer science, as explained by Raytheon.
Besides bombs, the bacteria can be engineered to detect a wide range of other threats, including contaminants. Another information the company shared is that the system will be modular.
Apart from the application for the military, these biosensors can also be useful in controlling the quality of the water supply and the air. The modular design will allow for the detection of a wide range of threats.
Featured Stories
Features - Mar 24, 2026
How to Use GeForce NOW to Play Video Games Without Actual Hardware
Features - Jan 29, 2026
Permanently Deleting Your Instagram Account: A Complete Step-by-Step Tutorial
Features - Jul 01, 2025
What Are The Fastest Passenger Vehicles Ever Created?
Features - Jun 25, 2025
Japan Hydrogen Breakthrough: Scientists Crack the Clean Energy Code with...
ICT News - Jun 25, 2025
AI Intimidation Tactics: CEOs Turn Flawed Technology Into Employee Fear Machine
Review - Jun 25, 2025
Windows 11 Problems: Is Microsoft's "Best" OS Actually Getting Worse?
Features - Jun 22, 2025
Telegram Founder Pavel Durov Plans to Split $14 Billion Fortune Among 106 Children
ICT News - Jun 22, 2025
Neuralink Telepathy Chip Enables Quadriplegic Rob Greiner to Control Games with...
Features - Jun 21, 2025
This Over $100 Bottle Has Nothing But Fresh Air Inside
Features - Jun 18, 2025
Best Mobile VPN Apps for Gaming 2025: Complete Guide
Read more
ICT News- Mar 24, 2026
OpenAI on the Brink: Major Setbacks Signal the Bursting of the AI Bubble
The era of unchecked AI hype appears to be ending, and the bubble is finally bursting.
Features- Mar 24, 2026
How to Use GeForce NOW to Play Video Games Without Actual Hardware
GeForce NOW makes PC gaming accessible to a wider audience by removing the barrier of expensive hardware.
Comments
Sort by Newest | Popular